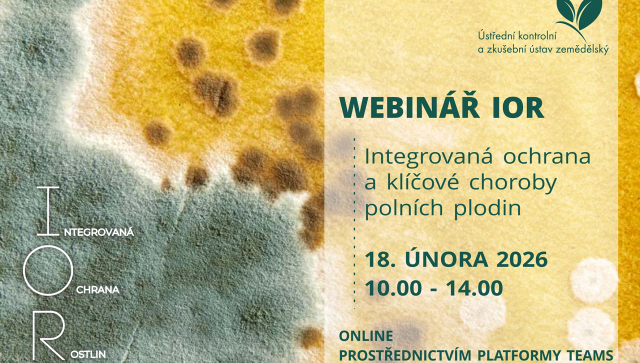

Pořadatel
Ústřední kontrolní a zkušební ústav zemědělský
ukzuz.gov.cz
Bližší informace
Integrovaná ochrana rostlin využívá všechny metody regulace škodlivých organismů a zohledňuje ekologické, ekonomické, toxikologické i hygienické požadavky. Záměrem je udržet populace škodlivých organismů na tolerovatelné úrovni, kdy nezpůsobují významné hospodářské škody. Využití chemické ochrany při regulaci škodlivých organismů není vyloučeno, k jejímu použití by však mělo dojít až poté, co selžou všechna ostatní opatření, která mají přispět k ochraně porostů pěstovaných rostlin a která se z různých důvodů dostala do pozadí.
Odborný webinář s názvem „Integrovaná ochrana a klíčové choroby polních plodin“ navazuje na námi pořádaný webinář o klíčových škůdcích polních plodin a v cyklu přednášek zaměřených na integrovanou ochranu rostlin je celkem již jedenáctý v pořadí.
Cílem letošního webináře je představit klíčové choroby hlavních polních plodin, stručně si připomenout jejich životní cyklus a zejména se zaměřit na způsoby jejich regulace ve smyslu preventivních postupů a biologické či botanické ochrany. Součástí webináře bude i připomenutí funkcí filtrů semaforu přípravků na ochranu rostlin Rostlinolékařského portálu.
Datum: 18. února 2026
Místo: Online (platforma Teams)
Přihlašování na akci probíhá prostřednictvím registračního formuláře. Více zde ↗